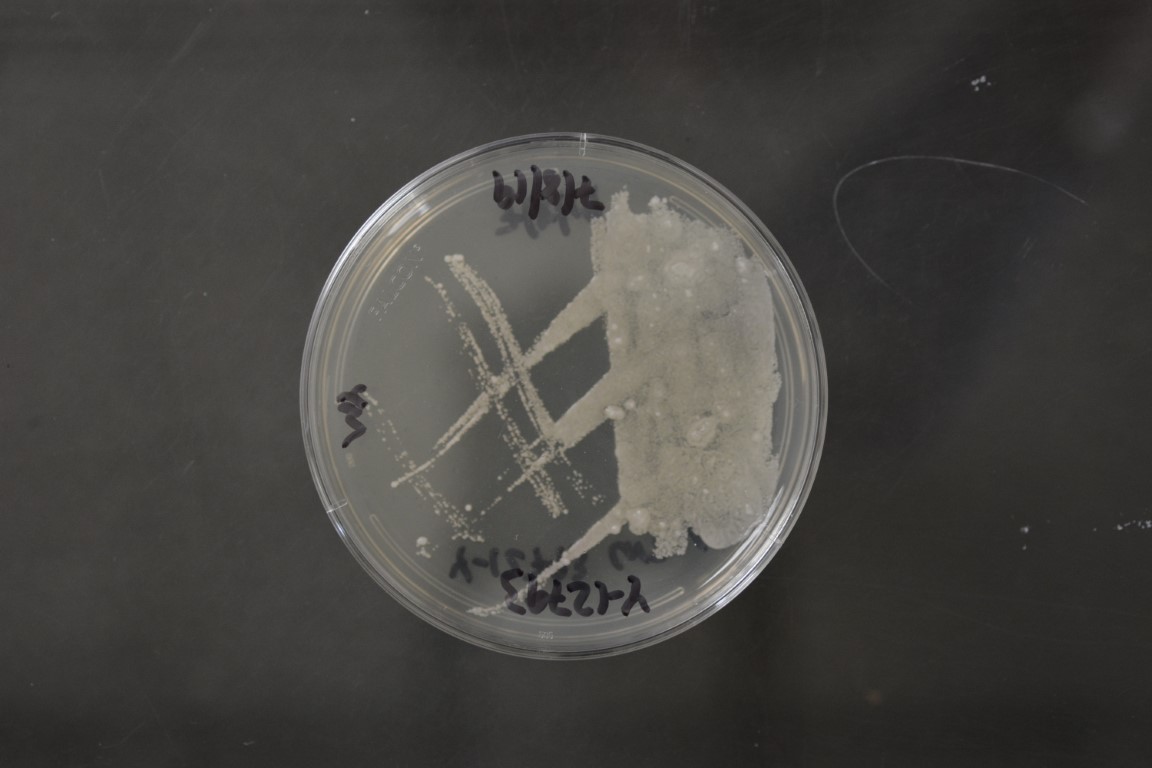

Saccharomycodes ludwigii
NRRL Y-12793(Type Strain)
Accession numbers in other collections:ATCC 11313=CBS 821=CCRC 21378=DBVPG 6721=IFO 0798=NCYC 731
Source:D.Yarrow,CBS,Delft,The Netherlands
Genetic info:ROBNETT PCR#258 and#862.0 diff.D1/D2 and MS with Y-12860,3 diff.ITS with Y-12860.GenBank:D1/D2(U73601),LSU(JQ689025),SSU(JQ698892),EF-1 alpha(JQ699049),RPB1(JQ713031),RPB2(JQ698963).
Growth media:Yeast Extract-Malt Extract-Peptone-Glucose(YM for yeasts)(number 6)
Optimum growth temperature:25C
Strain images:
NRRL_Y-12793_6.JPG